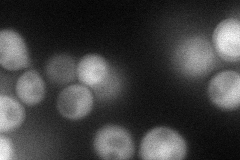
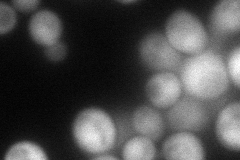

View description
Meiosis-specific protein that localizes to chromosomes, preventing synapsis between nonhomologous chromosomes and ensuring synapsis between homologs; complexes with Mnd1p to promote homolog pairing and meiotic double-strand break repair
Localization:
Intensity:
Fold change:
Significance:
-
C’ GFP library in SD

below threshold16.46 -
N' NOP1pr-GFP in SD
cytosol63.441 -
N' TEF2pr-mCherry in SD
cytosol82.3241 -
N' NATIVEpr-GFP in SD

punctate,mitochondria12.6845 -
N' TEF2pr-VC and Cyto-VN in SD

cytosol35.392 -
C’ GFP library in SD+DTT

cytosol16.090.97No -
C’ GFP library in SD+H2O2

cytosol14.730.89No -
C’ GFP library in Starvation Media

cytosol17.121.03No -
C’ GFP library on the background of Pup2-DaMP

below threshold -
C’ GFP library on the background of CCT mutant

below threshold16.12940.979159No
